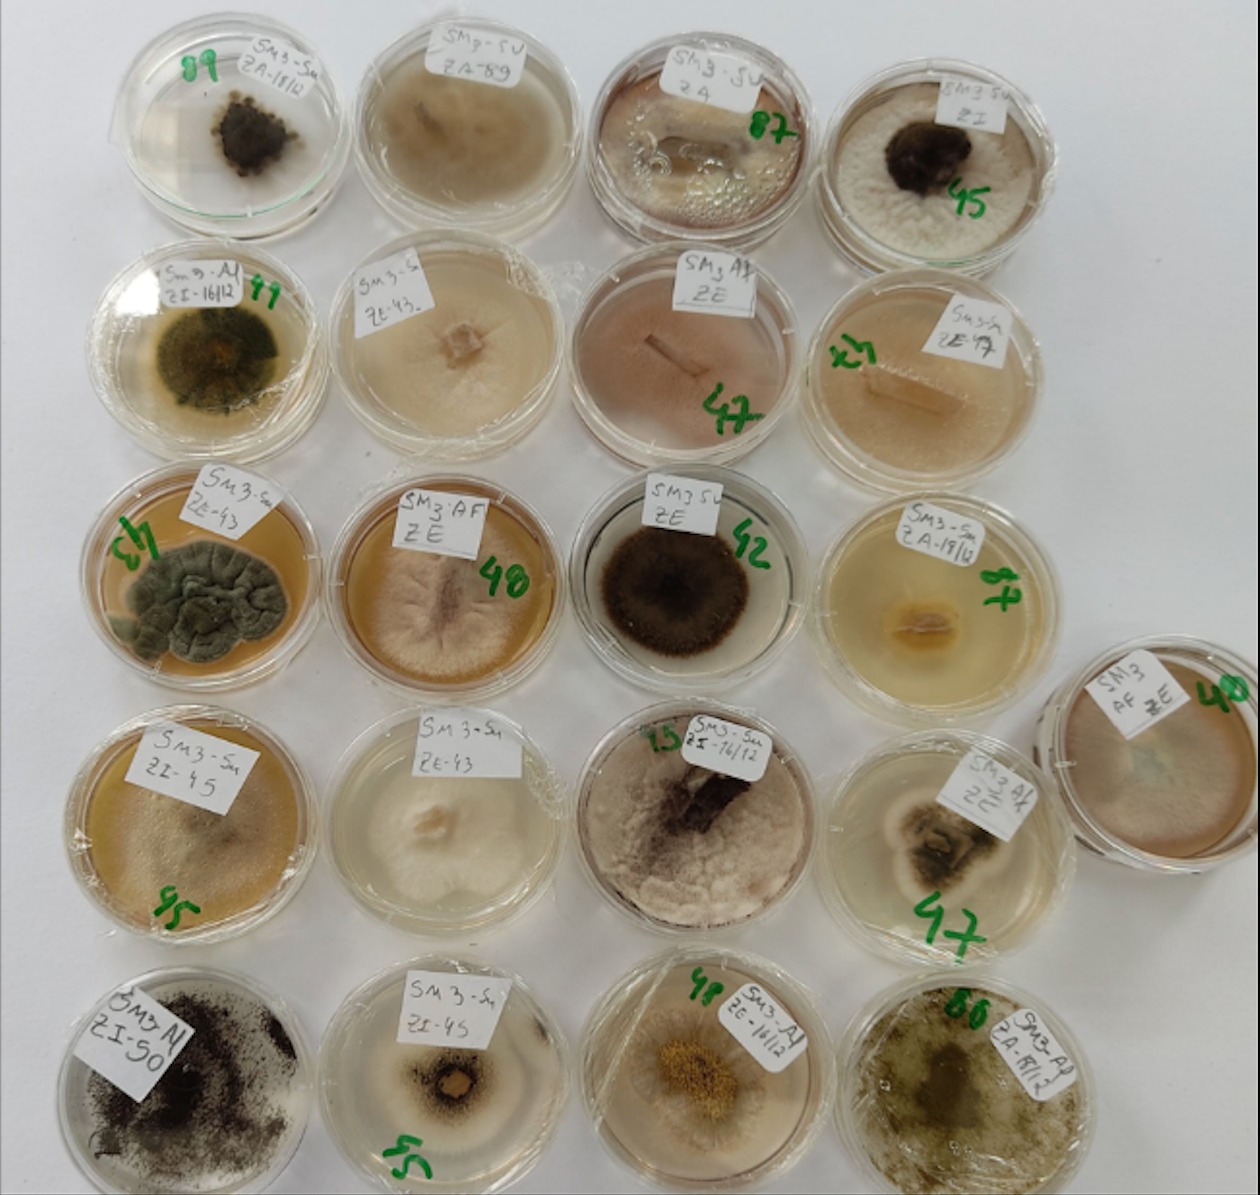
Pesquisadores da UEG descobrem novas espécies de cogumelo e bolor

Pesquisadores da UEG descobrem novas espécies de cogumelo e bolor
O cogumelo foi encontrado em área de mata da Floresta Nacional de Silvânia. Já o bolor foi localizado em uma das cavernas do Parque Estadual Terra Ronca, no município de São Domingos
A equipe do Laboratório de pesquisa da UEG, em Anápolis, descobriu recentemente duas novas espécies de fungos no cerrado. A primeira é um cogumelo e a outra, um bolor. As descobertas são parte da pesquisa de doutorado dos estudantes do Programa de Pós-Graduação em Recursos Naturais do Cerrado (Renac|UEG) Lucas Leonardo da Silva e Antônio Sérgio Ferreira de Sá, orientados pela professora doutora Solange Xavier dos Santos. Batizado como Furtadomyces sumptuosus, o cogumelo foi encontrado em uma área de mata da Floresta Nacional de Silvânia, uma unidade de conservação na região Centro-Sul do estado de Goiás, que abriga diferentes fisionomias vegetacionais típicas do cerrado. Segundo os pesquisadores, o nome foi dado devido às características do cogumelo, que é robusto, suntuoso, bem diferente do que se conhece como um cogumelo tradicional. Já o bolor foi encontrado em uma das cavernas do Parque Estadual Terra Ronca, localizado no município de São Domingos, no Nordeste do estado. O nome científico da espécie, Preussia bezerrensis, foi dado em homenagem à caverna onde ele foi encontrado, que é conhecida como Lapa do Bezerra. “A caverna é santuário natural, de rara beleza e muito difícil acesso e, por isso, a natureza lá se mantém quase intacta”, explica a professora Solange Xavier. Os resultados dessas descobertas foram publicados em 2022 nas revistas científicas internacionais Mycological Progress, volume 21, e Persoonia - Molecular Phylogeny and Evolution of Fungi, volume 49. Os pesquisadores Após a conclusão do doutorado, Lucas Leonardo da Silva candidatou-se a uma bolsa de pós-doutorado no mesmo laboratório. Sua pesquisa é focada no estudo dos fungos conhecidos como orelhas-de-pau do cerrado, que quase sempre crescem sobre madeira, são grandes e facilmente visíveis. Já Antônio Sérgio Ferreira de Sá está estudando os fungos que ocorrem em cavernas do cerrado. O pesquisador explica que entre esses fungos de ambientes cavernícolas, alguns oferecem risco para a saúde, como é o caso de algumas espécies que vivem associadas a fezes de morcegos, que podem causar séria infecção pulmonar se forem inaladas pelas pessoas que adentram essas cavernas. Esse foi, inclusive, um dos objetivos do estudo do Antônio Sérgio: verificar a ocorrência desses fungos nas cavernas do parque e, com isso, o risco de visitação turística nessas áreas. Informações/UEG




.gif)
.gif)










Facebook